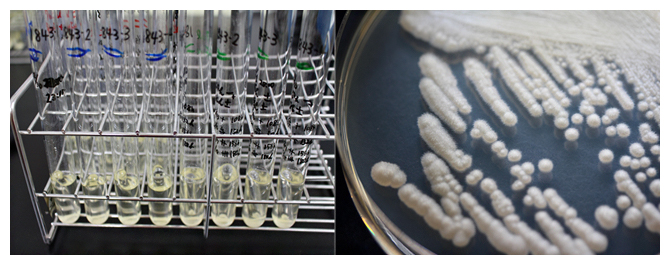
ブドウ糖・果糖の発酵能力試験の様子（左）と寒天培地上の酵母の図

理化学研究所(理研)バイオリソース研究センター微生物材料開発室の遠藤力也研究員、堀山麻衣子研究パートタイマーⅡ、大熊盛也室長の研究チームは、同室で生物遺伝資源として保存している酵母[1]388株を用いて、全ての株が果糖を栄養源として利用できること(資化[2])、302株(約78%)が果糖を発酵[3]できることを発見しました。
本研究成果は、生物遺伝資源として保存され、研究材料として利用される酵母の利用価値を高める基礎データとして重要であり、また、酵母の野外生態の解明にも貢献すると期待できます。
酵母には1,500以上の種が知られていますが、これまで、ブドウ糖やショ糖に対する酵母の発酵能力・資化能力のデータは充実している一方、果糖に関するデータはほとんどありませんでした。
今回、研究チームは、388株の酵母を用いて実験を行ったところ、全株が果糖に対する資化能力を持ち、302株が発酵能力を持つことを発見しました。この結果から、この二つの能力が酵母の普遍的な表現型[4]であることが明らかになりました。また、発酵においてAmbrosiozyma platypodisとCyberlindnera americanaの2株は、ブドウ糖と果糖を混合して与えた場合はブドウ糖を好み、ブドウ糖または果糖を単独で与えた場合は果糖を特に好むことが分かりました。
本研究は、科学雑誌『Microorganisms』(4月5日付:日本時間4月5日)に掲載されます。
背景
理研バイオリソース研究センター微生物材料開発室(BRC-JCM)は、文部科学省が推進するナショナルバイオリソースプロジェクトの中核的拠点「NBRP一般微生物」として、多種多様な微生物株を収集・保存・提供しています。幅広い研究コミュニティーにおいて品質の確かな微生物株を利活用してもらうために、保存する微生物菌株の品質管理は極めて重要なミッションです。このうち、酵母株については、その菌株が持つ特性「表現型」の品質管理を行ってきました。例えば、「ブドウ糖(グルコース)をアルコール発酵(以下、発酵)する」という能力も、その菌株の表現型の一つといえます。
酵母といえばモデル生物であり、パン酵母や清酒酵母とも呼ばれるSaccharomyces cerevisiae(サッカロマイセス セレビジエー)が特に有名ですが、酵母には1,500以上の種(species)が知られています。顕微鏡で観察しても形態の特徴が乏しいことから、酵母の種の識別・分類には生理学的特徴を指標とする手法が古くから用いられてきました。その手法は1950年頃には既に体系化されており、糖類の発酵能力や炭素源の資化能力など30以上の項目が識別の指標に含まれています。生理学的特徴の解析は標準法として現代の酵母研究でも広く行われており、ほぼ全種の酵母で生理学的特徴のプロファイルが明らかにされています。
研究チームは、BRC-JCMにおいて酵母の表現型の品質管理を進めていく過程で、ブドウ糖やショ糖(スクロース)の発酵能力・資化能力のデータは充実している一方、果糖(フルクトース)に関するデータはほとんどないことに気付きました。古い文献を当たると、1912年頃に「ブドウ糖を発酵できる酵母は例外なく果糖も発酵できる」とした記述があり、1952年に出版された酵母分類の標準書『The Yeasts, a Taxonomic Study』ではこの説を採用して、標準法として生理学的特徴解析の対象に果糖を含まなかったことが判明しました。のちの1985年にこの"ルール"を再検証し、「概ね正しい」とした文献があるものの、どの酵母種を用いて検証したかといった詳細が記述されていないことも分かりました。
このような歴史的背景から、酵母の生理学的特徴のプロファイルにおいて、果糖のデータが事実上欠落している状態が続いていました。
研究手法と成果
研究チームは、BRC-JCMで生物遺伝資源として保存している酵母のうち、その種の代表とされる基準株を中心とした388株を用いて、ブドウ糖を発酵できる酵母は例外なく果糖も発酵できるかどうか検証しました(図1)。
図1 ブドウ糖・果糖の発酵能力試験の様子(左)と寒天培地上の酵母
- 左:左4本の試験管がブドウ糖、右4本の試験管が果糖の発酵試験。試験管内には小さな発酵管(ダーラム管)が逆さになって入っており、発酵に伴って発生する二酸化炭素を捕集することで発酵能力を観察できる。
- 右:寒天培地上に生育する酵母Ambrosiozyma platypodis JCM 1843株。
従来から行われてきた発酵能力・資化能力試験の手法を用いて実験した結果、388株全てで果糖の資化能力があること、302株で果糖の発酵能力があることが分かりました(表1)。
![]() 左右にスクロールできます
左右にスクロールできます
| 糖類 | 本研究 | The Yeasts | ||
|---|---|---|---|---|
| 資化能力あり | 発酵能力あり | 資化能力あり | 発酵能力あり | |
| ブドウ糖 | 100% (388/388) | 77.8% (302/388) | 100% (827/827) | 72.8% (602/827) |
| 果糖 | 100% (388/388) | 77.8% (302/388) | (データなし) | (データなし) |
| ショ糖 | 59.0% (229/388) | 25.5% (99/388) | 60.7% (502/827) | 24.2% (200/827) |
| ガラクトース | - | - | 65.4% (541/827) | 30.6% (253/827) |
| トレハロース | - | - | 70.0% (579/827) | 30.1% (249/827) |
| 麦芽糖 | - | - | 56.8% (470/827) | 18.3% (151/827) |
| ラフィノース | - | - | 28.5% (236/827) | 13.8% (114/827) |
表1 各種糖類の資化能力・発酵能力を持つ子嚢菌酵母の割合
本研究ではブドウ糖・果糖・ショ糖の資化能力および発酵能力を試験した。右2列のデータは『The Yeasts, a Taxonomic Study 第5版』(2011年)より集計し、カッコ内の数値は種数で計数した。ブドウ糖と果糖で数値が突出して高く、酵母が好む糖類であることが分かる。
また、Ambrosiozyma platypodis、Cyberlindnera americana、Sporopachydermia quercuumという酵母では、大半の酵母とは異なる発酵能力を示すことが分かりました。Ambrosiozyma platypodisとCyberlindnera americanaでは、ブドウ糖よりも果糖を好んで発酵能力を発揮する様子が観察されました。一方で、Sporopachydermia quercuumではブドウ糖を発酵するものの、果糖は発酵しないという例外的な結果も得られました(表2)。
![]() 左右にスクロールできます
左右にスクロールできます
| 種名 | JCM no | 資化能力 | 発酵能力 | ||||
|---|---|---|---|---|---|---|---|
| ブドウ糖 | 果糖 | ショ糖 | ブドウ糖 | 果糖 | ショ糖 | ||
| Ambrosiozyma platypodis | 1843T | + | + | + | w | + | - |
| Ambrosiozyma platypodis | 1796 | + | + | + | +/s | + | - |
| Cyberlindnera americana | 3592T | + | + | + | - | +/s | - |
| Cyberlindnera americana | 3593 | + | + | + | w | s | - |
| Sporopachydermia quercuum | 9486T | + | + | - | + | - | - |
| Saccharomyces cerevisiae | 7255T | + | + | + | +ST | +ST | +ST |
表2 発酵試験において例外的な反応を示した酵母
+:陽性(能力あり)、-:陰性(能力なし)、+ST:強い陽性、s:緩やかに陽性、w:弱い陽性。Ambrosiozyma platypodisとCyberlindnera americanaでは果糖を好んで発酵した。JCM noは菌株固有のIDを示す。
さらに、発酵試験で特徴的な反応を示したAmbrosiozyma platypodis JCM 1843とCyberlindnera americana JCM 3592に注目し、ブドウ糖を単独で与えた場合、果糖を単独で与えた場合、ブドウ糖と果糖を混合して与えた場合で、発酵の最中にどのように糖類が消費されていくかを測定しました。その結果、両者ともSaccharomyces cerevisiaeに比べて、糖類を単独で与えた場合は果糖をより消費し、混合して与えた場合はブドウ糖をより好んで消費することが分かりました(図2)。不思議なことに、果糖が同時に存在することで、ブドウ糖の消費が活性化するという現象も観察されました(図2)。

図2 発酵試験におけるブドウ糖・果糖の消費プロファイル
試験開始時(0時間)の糖類存在量を100%として、ブドウ糖・果糖が発酵液中で徐々に消費されていく様子が分かる。左の三つのグラフはブドウ糖・果糖をそれぞれ単独で酵母に与えた場合、右の三つのグラフはブドウ糖・果糖を混合して酵母に与えた場合の変化を示す。Saccharomyces cerevisiae(下段)と比べて、Ambrosiozyma platypodis(上段)とCyberlindnera americana(中段)では糖類を単独で与えた場合に果糖をより消費した。また、果糖が同時に存在することで、ブドウ糖の消費が活性化することも分かった。シンボル(□、〇)上下のバーは標準偏差を、アスタリスク(*)はブドウ糖の値と果糖の値の間に有意差があることを表す。
本研究により、酵母の幅広い種が果糖の資化能力および発酵能力を持っており、酵母の普遍的な表現型であることが明らかになりました。これは、これまで見過ごされてきた果糖の資化能力・発酵能力を"再発見した"といえます。掲載された論文中では、実験に用いた全ての酵母菌株の番号とその能力プロファイルを明示し、生理学的特徴データの欠落を埋めることができました。
今後の期待
本研究成果は、生物遺伝資源として保存され、研究材料として利用される酵母の利用価値を高める基礎データとして重要です。本研究が契機となり、酵母による果糖の利用特性のデータが今後さらに蓄積していくことが期待できます。
果糖はフルーツをはじめとして自然界に広く存在する、人類にとって身近な糖類です。本研究により、酵母がブドウ糖と同じように果糖を好むことが明らかになりました。しかし、ブドウ糖を好む酵母のほぼ全てが、なぜ果糖も好むのかは依然として謎です。実は、多くの酵母種でその野外生態は解明されていません。酵母が普遍的に持つ果糖の資化能力と発酵能力は、酵母が野外で生存していく上で欠かせない能力と考えられます。本研究は、実験室内で培養した酵母株の品質管理を端緒として実施したものですが、酵母の野外生態の解明にも貢献すると期待できます。
補足説明
- 1.酵母
微生物は、細胞に核を持つものと持たないものに大別される。細胞に核を持つ微生物のうち、生活環(ライフサイクル)の一部または大半を単細胞で生育するものを酵母という。パン酵母 Saccharomyces cerevisiae(サッカロマイセス セレビジエー)や分裂酵母 Schizosaccharomyces pombe(シゾサッカロマイセス ポンビー)はモデル生物として特に有名で、細胞生物学や分子生物学など幅広い分野で学術研究に利用されている。 - 2.資化
微生物がある化合物を栄養源として利用することを資化という。例えば、パン酵母は炭素源として果糖を利用でき、果糖の資化能があるといえる。 - 3.発酵
微生物による代謝活動のうち、その産物や代謝活動の結果が人間にとって有益な場合を特に「発酵」という。例えば、酒類の醸造に利用される代謝は「アルコール発酵」、漬物の製造に利用される代謝は「乳酸発酵」と呼ばれる。本研究で研究対象としたのは酵母によるアルコール発酵である。「発酵」とは逆に、代謝産物などが有害な場合は「腐敗」と表現される。 - 4.表現型
形態、構造、行動、生理学的性質など、生物の観察可能な特徴のことを表現型という。酵母においては、代謝能力の有無や栄養要求性といった生理学的性質が種や菌株を特徴づける表現型の一つとなる。
研究支援
本研究は、JSPS科研費JP 19K06160、JP 19H05689の助成を受けたものです。
原論文情報
- Rikiya Endoh, Maiko Horiyama, and Moriya Ohkuma, "D-Fructose assimilation and fermentation by yeasts belonging to Saccharomycetes: Rediscovery of universal phenotypes and elucidation of fructophilic behaviors in Ambrosiozyma platypodis and Cyberlindnera americana", Microorganisms, microorganisms9040758
発表者
理化学研究所
バイオリソース研究センター 微生物材料開発室
研究員 遠藤 力也(えんどう りきや)
研究パートタイマーⅡ 堀山 麻衣子(ほりやま まいこ)
室長 大熊 盛也(おおくま もりや)
報道担当
理化学研究所 広報室 報道担当
お問い合わせフォーム
